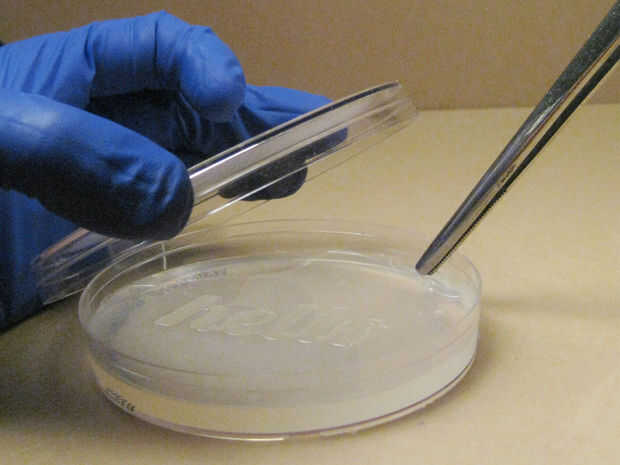

Paso 7: Coloque la plantilla

Voltear el plato y abra cuidadosamente la tapa. Utilice las pinzas y Coloque suavemente la plantilla estéril sobre el agar sólido. Asegúrese de que su plantilla se coloca en el lado derecho para crecer su diseño.
Para evitar la contaminación adicional, también puede colocar la placa con la plantilla durante 30 min bajo luz UV antes de aplicar el cultivo microbiano.